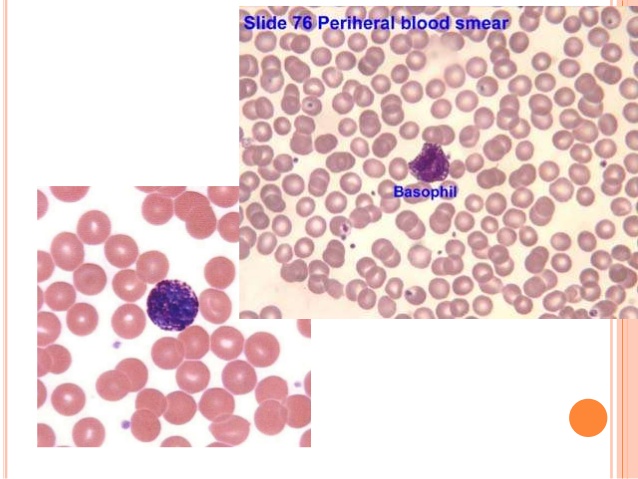

Dysthymia, sometimes referred to as mild, chronic depression, is less severe and has fewer symptoms than major depression. With dysthymia, the depression symptoms can linger for a long period of time, often two years or longer. Those who suffer from dysthymia can also experience periods of major depression--sometimes called "double depression." In modern diagnostic classification systems, dysthymia and chronic depression are now both referred to as 'persistent depressive disorders.

- From: Sunday 15 July 2018
- To: Saturday 15 September 2018
-
If you have any Dental Problem, KayaWell Expert Dr. Nitika Jain is providing free dental consultation for KayaWell users.
Every First Saturday of Month


 Contact Us
Contact Us






 Hospitals
Hospitals
 Doctors
Doctors
 Diagnostic
Diagnostic
 Pharmacy
Pharmacy
 Health Tips
Health Tips
 Blog
Blog